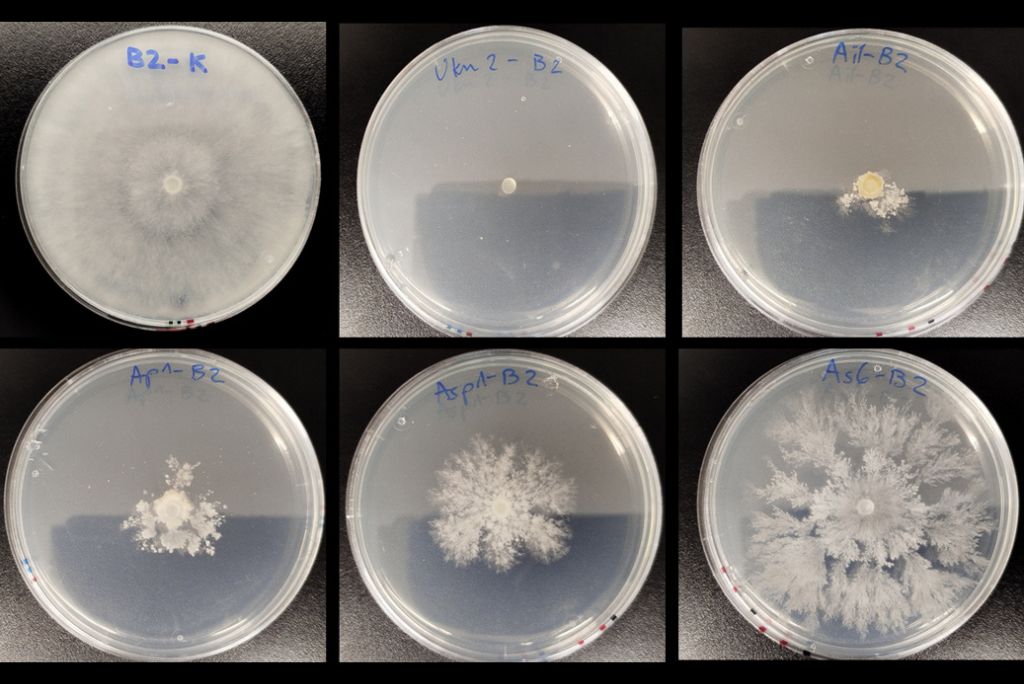
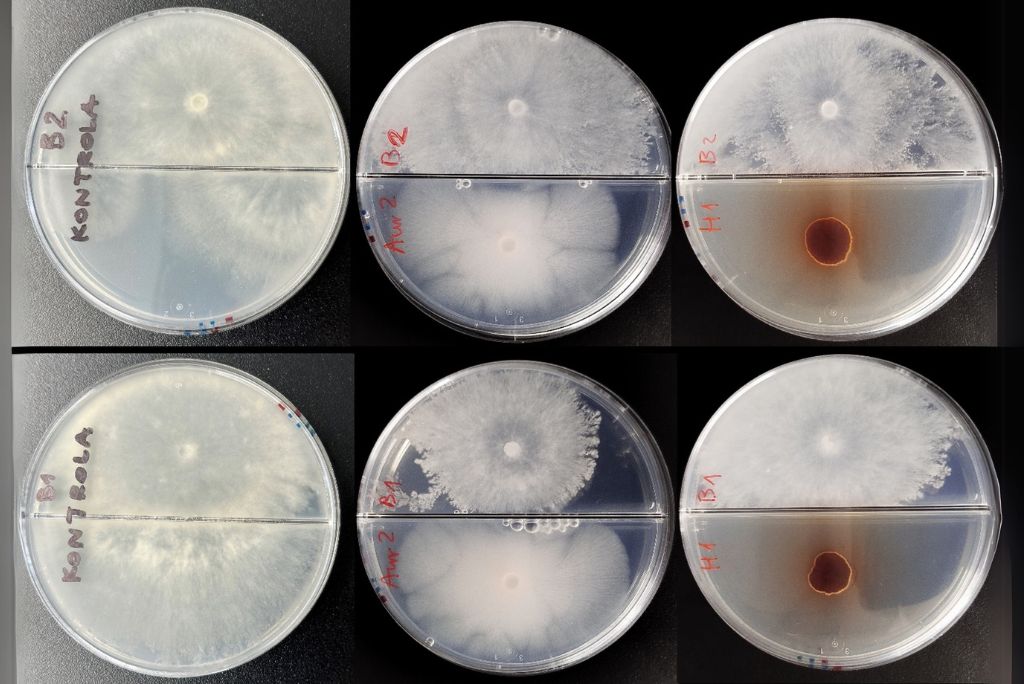
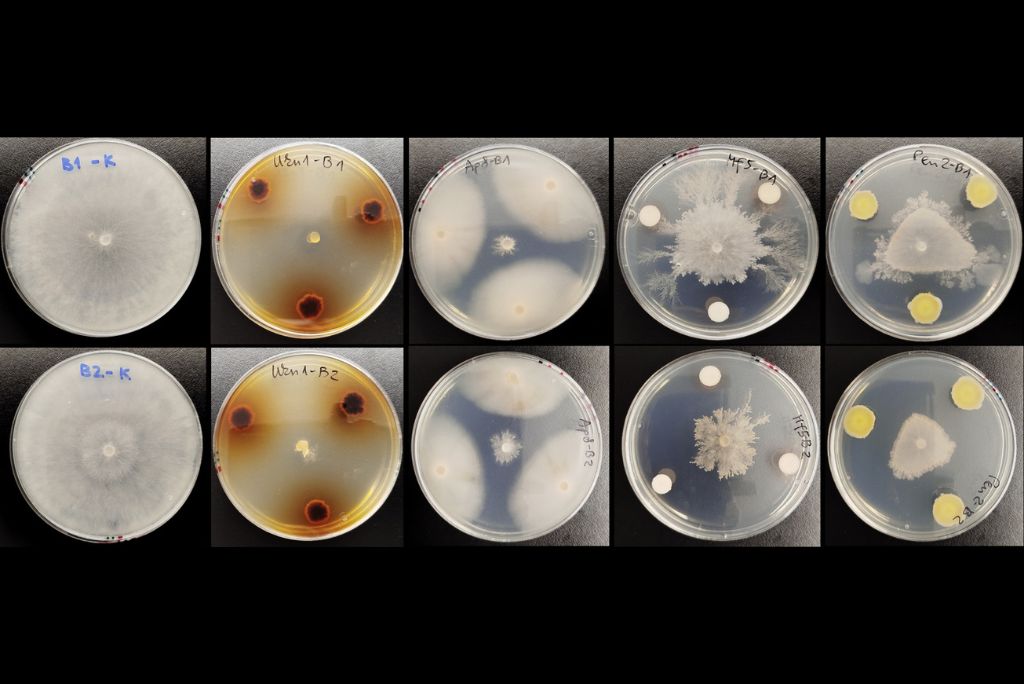
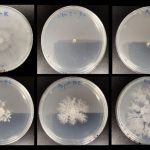
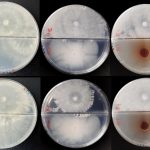
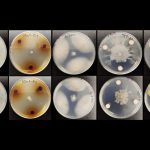

J4-50140: Novel biocontrol fungi for sustainable strawberry production
Project description
Modern and healthy eating habits have led to a growing demand for fresh fruit in Europe, and thus to increased berry production. The cultivation of soft fruits such as strawberries, blueberries and raspberries has become particularly attractive for specialisation by smaller companies in Slovenia. Berries are rich in vitamins, antioxidants and fibre, their production has a high added value and can contribute to rural development strategies.
Botrytis species, in particular Botrytis cinerea, which is recognised as the second most important plant pathogen, cause soft rot (grey mould) in more than 500 plant species. Soft fruits such as strawberries are particularly prone to mechanical damage and susceptible to decay caused by fungi before or after harvesting. The strategy for the control of Botrytis spp. involves several fungicide applications during the growing season. However, the rapid development of multiple fungicide resistance critically reduces the effectiveness of chemical control. In addition, the long-lasting and dangerous effects of fungicides on the environment and humans have been a matter of public concern for decades. Alternative approaches that reduce the use of fungicides in agriculture are driving national and European strategies for more sustainable and organic methods of food production. One of the most promising approaches is the use of products for biological plant protection purposes based on antagonistic micro-organisms (biological agents), such as yeasts and fungi, which prevent the growth of plant pathogens. The limited effectiveness of such agents makes the search for strains with more potent activity very topical. In addition, very little information is available on the mechanisms of action of biological agents and unravelling their mode of action will be an important contribution to science and the profession.
Based on the reduced efficacy of chemical fungicides against B. cinerea due to the emergence of resistance, the increased demand for organic farming and the increase in berry production, we have designed a research project to search for antagonistic fungi to inhibit the growth of pathogenic fungi. The primary focus is on the control of Botrytis spp. and against the other two most important strawberry diseases; these are strawberry powdery mildew – Podopshaera aphanis and anthracnose caused by Colletotrichum acutatum. The project will, among other things, discover new principles of interactions between non-commercialised fungal strains that inhibit the growth of Botrytis spp. with soluble secondary metabolites. The wide range of phylogenetically diverse fungi available in the KIS and Ex collections will be included in screening assays to detect antagonistic growth inhibitory properties of Botrytis spp. in vitro and in vivo. The isolates with the best antagonistic activity against Botrytis spp. will also be tested against P. aphanis and C. acutatum. The mode of antagonistic action and interactions with Botrytis spp. will be investigated by transcriptomic and metabolomic analyses. Comparisons between active and inactive strains of the same species will be used to determine the soluble and volatile organic components associated with antagonism and to identify genes specifically expressed during the antagonist-pathogen interaction.
The efficacy of antagonistic fungi to inhibit the growth of pathogens on strawberry plants and fruits under laboratory conditions often does not coincide with the efficacy under realistic outdoor production conditions. Therefore, we will conduct an in planta experiment in which we will use a selected antagonistic fungal species for the purpose of biological protection of the strawberry field. The efficacy of the selected fungal strain will be evaluated by means of hyperspectral imaging to detect the health status of the plants and changes in their physiology, which will be linked to chemometric analyses of leaves and harvested fruits.
The results of this project will identify new useful strains of antagonistic fungi for biological control of Botrytis spp. We will study the transcriptional response of the fungi on the fruits of strawberry plants, thus gaining important knowledge on the mechanisms of action of the antagonistic fungi. In addition, we will make an important contribution to the evaluation of plant health after the application of biological agents by introducing a high-throughput hyperspectral imaging method and developing predictive models of strawberry quality. The results obtained in the course of the project will allow the discovery of useful properties and principles of action in biological plant protection, which could lead to commercialisation and practical application in strawberry production in the future.
Objectives
Each of the proposed objectives of our project below addresses key challenges facing agriculture, including (a) the development of coexisting resistance to different fungicides in Botrytis spp., in particular B. cinerea, (b) the urgent need to develop sustainable, environmentally friendly plant protection products (replacing synthetic fungicides in agriculture with biotic protection products) and (c) the increased production of value-added berries (fruits rich in vitamins, antioxidants and fibre), which are becoming increasingly economically important for (Slovenian) farmers).
Objectives of the proposed project are:
- To resolve the taxonomic diversity of Botrytis species, that are resistant to fungicides, encountered in Slovenian fruit productions centres.
- To study the antagonistic potential of candidate fungal species against Botrytis spp., P.aphanis and acutatum in in vitro tests and in vivo tests on strawberries to select most effective strains.
- Test the effectiveness of the selected antagonist in planta experiment, to monitor plant metabolic defence response and evaluate the quality of the fruit thus obtained.
- To understand the factors and mechanisms that determine the beneficial interaction between the antagonist and the plant pathogen through experiments by applying metabolomic and transcriptomic approaches.
Activities
The work of the project is divided into five work packages, the first four of which address the objectives described above. The fifth work package is dedicated to the dissemination of the results.
Work Package 1 – Antagonistic and pathogenic fungal strain collections: The aim of the first work package is to prepare collections of potential antagonistic strains of (yeast-like) fungi and select a number of Botrytis spp. strains covering the diversity of species and pathotypes seen in Slovenia.
Work Package 2 – In vitro antagonism of beneficial fungi against strawberry pathogens: The list of fungal candidate antagonists will be screened for their antagonistic activity against selected Botrytis spp., P. aphanis and C. acutatum will be investigated in different in vitro assays: by co-culture (dual culture plate – DCP), soluable organic compound (SOC) and volatile organic compound (VOC) assays.
Work Package 3 – In vivo antagonism of selected fungi against strawberry pathogens: Some of the most effective strains with the highest antagonistic activity detected in in vitro screening tests will be tested for their ability to inhibit the growth of Botrytis spp., P. aphanis and C. acutatum by inoculation of surface sterilised fruits/leaves and by excretion of volatile organic compounds.
Work Package 4 – In planta experiments for assessing suppression of strawberry pathogens: In this work package we will test the efficacy of a selected antagonistic fungus on strawberry plants by evaluating disease symptoms. The metabolic response of the plant will be monitored and the quality of the fruit thus obtained will be evaluated. We will combine chemometric and hyperspectral phenotyping analyses. Hyperspectral imaging will allow us to describe the phenotype of each plant in more detail and to assess empirically the impact of experimental treatments on plant physiology and leaf structure. In addition, by combining machine learning regression algorithms with chemical analyses, we will bea ble to develop new methods for chemometric analysis, such as the prediction of the amount of primary and secondary metabolites. These methods will then facilitate further research and development of models for predicting strawberry quality.
Work Package 5 – Analysing the mode of action of candidate antagonists against strawberry pathogens: In this work package, we will investigate the mode of action of selected strains of potential antagonistic fungi against Botrytis spp. We will determine the production of siderophores, enzymes and other soluble and volatile compounds of the most effective fungal strains. We will also examine the gene expression of potential antagonistic fungi and the tested Botrytis spp. strains in a differential approach.
Work Package 6 – Project management and result dissemination:The work will follow a task distribution, with each work package focusing on the achievement of milestones that affect the timing of the rest of the project. The results of the project will be of interest to the scientific and general public; we therefore plan to publish our results in scientific journals as well as in popular science journals reaching a broader readership, at conferences and professional meetings.
Results
Summary of results achieved up to the present:
In the first half of the project (from September 2023 to March 2025), we focused on achieving the first two objectives, (1) to resolve the taxonomic diversity of fungicide-resistant Botrytis species and strains in Slovenian strawberry fields and (2) to study the antagonistic potential of selected beneficial fungi against key pathogens of strawberry.
Under Objective 1, a collection of Botrytis spp. strains isolated from strawberry fields across Slovenia was established. The collection was compiled with the active participation of strawberry growers and additional field sampling. Molecular identification by sequencing of the NEP1 and G3PDH genes showed that the Slovenian population of Botrytis spp. almost exclusively belongs to species B. cinerea, with low genetic variability. Only one isolate was identified as the fungus B. pseudocinerea and no B. fragariae species were detected. The resistance test to three commonly used fungicides (cyprodinil, fludioxonil and fenhexamid) showed a high level of resistance: about 30% of the isolates were resistant to all three compounds. These results support the need to develop alternative, non-chemical approaches to plant protection against grey mould.
In parallel, we have established a collection of antagonistic fungal strains, mainly from the genera Aureobasidium, Metchnikowia, Candida, and others, with previously known potential for use in biological plant protection.
In the framework of Objective 2, the antagonistic activity of selected strains against the growth of fungi B. cinerea, C. acutatum and P. aphanis was evaluated in different in vitro assays (double culture test, soluble organic compound test and volatile organic compound test).
- In the dual culture tests, 56 % of the isolates strongly inhibited the growth of the fungus cinerea.
- In the soluble compound tests against the growth of the fungus cinerea, 64 % of the strains showed strong inhibition, while in the volatile compound tests it was less pronounced.
- Similar trends were also observed in the tests with the fungus acutatum, where 41 % of the strains strongly inhibited the growth of the pathogen and the other 59 % moderetly inhibited the growth.
- In the soluble compound tests, 83 % of the antagonistic fungal strains strongly inhibited the growth of pathogen C. acutatum, while in the volatile compound tests 33 % of the strains did so.
The most promising strains are included in in vivo tests on sterilised fruits and leaves, where their efficacy in inhibiting infections will be tested under conditions comparable to those in outdoor cultivation in the remainder of the project.
Obtained results were presented at a national expert meeting (23rd Strawberry Consultation) and at the IOBC-WPRS International Congress in Poland.
[1] COBISS ID: 217699331
[2] COBISS ID: 212325123